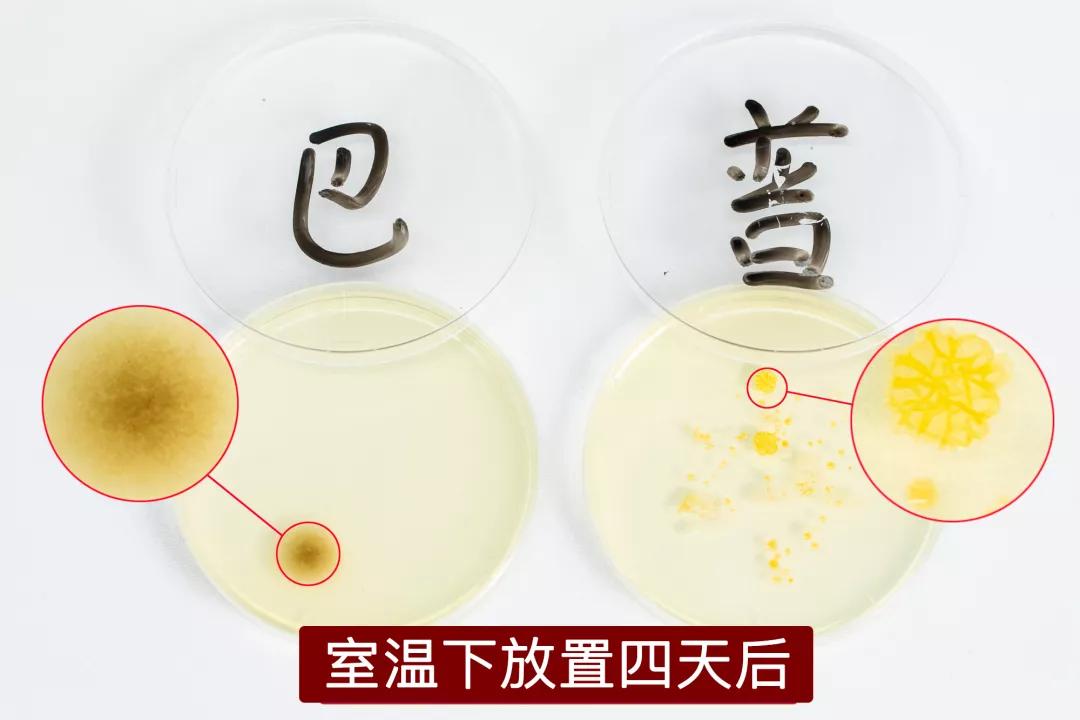
日本黑科技发明厨房,日本发明黑科技棺材车

互联网时代的“匠人”,大多掺杂了想割韭菜的水分。
万科王石也说过:“中国无论是互联网还是传统企业,都缺少日本的工匠精神,少了把一个产品当成艺术、生命去做的精神。”

尤其是在产品设计中,日本人更在乎简单的舒适体验。对于他们来说,创造新的产品很容易,难的是让它一直流传下去。
原研哉在《设计中的设计》中提过一个概念:RE-DESIGN/重新设计。在科技发展时,改变从前受制约、有遗憾的设计,让人的体验更舒服。

一个普通的风扇,当大家还在纠结风扇的性能时,有人会探寻什么风吹出来更舒服;
空气污染的大环境下,当大家在讨论滤网的等级时,有人在思考如何改变室内的空气流动;
室内干燥,大家在关心加湿器的效率时,有人却在重新定义空气湿度的意义。

这就是巴慕达。其创始人寺尾玄被媒体比作为日本的乔布斯。毕竟他也做到了让巴慕达摸着石头过河,其他品牌踏着巴慕达过河。
就拿巴慕达的Rain·加湿器来说,推出5年之久,仍然代表目前为止家用加湿器所能达到的顶峰。

巴慕达创始人寺尾玄在创作Rain智能加湿器的时候,为在加湿方式与加湿效果取得突破,几乎走遍日本图书馆,拜访工厂与团队彻夜讨论。
但一次雨中偶然的行走,呼吸到湿润而又清新的空气时,就让他确定了巴慕达加湿器的方向。

将设计做到舒适的产品都会让人感觉恰到好处,少一点有遗憾,多一点则冗余。当然这背后离不开上万次的推倒重来。

杀菌效果达99.99%,使用气态水加湿,还能清洗空气。
这是在地球上,见到的不用开盖就能屏上加水的加湿器,它已经跳出了“加湿器”范畴的革新式机器。

推荐理由:
1、30分钟给燥热暖气房/空调房降温4.9℃,60分钟给室内加湿510ml,90分钟给室内空气去除91%的病毒细菌。
2、可以使用自来水的加湿器,4.2L-6L广口大水箱,清洗方便,使用省心。
3、不出水雾、没有*粉白**,使用气态水实现整屋加湿。
4、三重净化装置,央视CCTV1频道盲测认证。99.99%除菌率,拒绝“加湿器肺炎”。

加湿器只能靠水雾加湿?不,巴慕达让空气自己变得湿起来。
通过循环风将液态水变为气态水,从而给空气加湿。启动时只有微风,但湿度在悄无声息中上涨。

独有汽化技术:无水雾、无水垢、无细菌
市面上常见的加湿器分三类,但汽化式/冷蒸发式无论从体验上,还是健康来说都是优选。
甚至国外某些上层场合都要求,只允许使用汽化式加湿器。



小实验:无水雾 脏东西不再入肺
我们做了个实验,在水箱里加入蓝色墨水后启动普通超声波加湿器与巴慕达汽化式加湿器。(小口的下加水设计简直反人类)

再将鲜花放在加湿口处。
普通加湿器这边虽然水雾仍旧正常,但鲜花上已经沾满蓝色。但巴慕达处的鲜花,毫无变化。

也就是说,在加湿时,水中的杂质会随着超声波加湿器的雾气,一同震荡到空气中,然后被吸入肺部。
而巴慕达Rain则通过蒸发将液态水变为气态水从而实现加湿,当然不会把水中杂质、细菌带出。

虽然某些售价高昂的超声波加湿器会掩盖掉水雾,启动时看不出,但侧面就漏了馅。比如这台售价3890元的戴S。

加湿量够猛!找回夏天的湿润
在加湿性能上,巴慕达宣称5档510ml/h的加湿量,几乎能回到“面朝大海,不干不燥”的夏天。如果全天开启第五档,甚至能体会到南方梅雨季的感受。

实验①:1小时590ml水!多加湿一倍
而友商,根据详情页宣传的“3L水箱、18小时加湿”,换算一下,约等于166.7ml/h,小半杯的量。

档数开到顶,我们实测对比了二者的一小时加湿量。(巴慕达为5档,戴S为10档)

巴慕达一小时加湿量0.59公斤/590ml,约摸一瓶脉动。而友商戴某,一小时加湿量0.3公斤/300ml。
虽然都比宣称得要高,但明显巴慕达更好。

相差不少的加湿量作用到实际物体上时,表现更为直观。

实验②:加湿8小时 花朵保持鲜嫩
我们做了一个不严谨的实验,观察鲜花与加湿器同处于密闭空间内的状态,上午上班时放入,下午下班前取出(8个小时左右)。
加湿前花瓣均向上、花朵硬挺向上

8小时之后,戴S这边的花朵呈微垂状态,花瓣呈四散状态,当然也不排除它突然想开了。
而巴慕达的花朵与花瓣,与之前没什么变化。

近距离观察细节,差距更明显了。

大空间 有暖气照样增湿快!
在实际房屋加湿能力上,同时开启电暖气和加湿器高档50分钟进行实测(巴慕达5档,戴森10档)。


虽然电暖气有增湿效果,房屋湿度不会太低,但巴慕达依旧表现出色。

中国家用电器检测所的检测报告,认证加湿量与加湿效率与宣称无误。

在实际体验这段时间,一台巴慕达就能搞定整屋加湿,放在卧室,不关房门都能照顾到客厅。
湿度、温度、空气清新度都很舒适,就像重新回到了南方海滨城市一样,嗓子也不会被“干到发疼”。


为什么要换一个堪称加湿器领域堪称“爱马仕”级别的巴慕达?很大原因是基于对健康的考虑。
*粉白**堆积,漏水,不静音,频繁加水…都能忍,但新闻爆出“加湿器会引发加湿性肺炎,尤其是婴幼儿及老人”时,还能忍吗?

三重净化装置:自来水、矿泉水都行
就拿“加湿器要求加纯净水”这件事来说,超声波加湿器,普遍没有过滤装置。加湿时会将水中杂质、细菌带到空气中。
无论自来水,还是纯净水,都无法做到无菌。就算有除菌功能,品牌方仍建议使用纯净水加湿(这加得可是钱),比如这台知名友商的加湿器。
(*自来水中每毫升含有100CFU以下菌落总数;纯净水每毫升含有20CFU以下菌落总数。)

否则用久了,就会“揭盖有惊喜”。

而巴慕达原理是用风扇加速水的蒸发,并非外力打散,不会将水中杂质带出。并且还有三重净化装置保障健康。

水箱底部的银离子环能抑制水变质、产生粘液;
水箱中部的加湿滤网,过滤水中杂质;
水箱顶部的溶菌酶滤网溶解空气中细菌和病毒,并过滤灰尘。
小实验:培养皿真实测试 放心
我们又做了一个不严谨的实验,将两个培养皿同时放在普通加湿器与巴慕达加湿器的加湿口(均使用自来水),然后在室内温度下放置4天。
*同时暴露于空气中,停留在不同加湿口后封闭放置。

结果显而易见,普通加湿器的培养皿中出现了大大小小的白点,这些白点就是细菌。
而巴慕达加湿器的培养皿中,仅有一处,可以保证它在加湿时的水分是无菌的(生菌越少代表越纯净)。
中国家用电器检测所的报告,认证巴慕达的除菌率,可以达到>99.99%。

此外水箱不方便清洗也是致命的缺陷,而“加湿器引起肺炎”的原因,就在于水箱。


“清洗空气” 只要30分钟
不仅过滤水中细菌,经过严密设计的风道循环系统,巴慕达还能做到“清洗空气”。

通过在25m³房间内进行的试验证明,30分钟内可去除85%的病毒和细菌;90分钟内可去除91%的病毒和细菌。
加湿后,就像春雨里洗过的空气一样,又润又鲜。
▽日本食品分析中心实验结果▽

日本食品中心的实验报告如下,这是日本分析试验机构,符合医疗仪器、化学物质GLP以及农药GLP的试验标准。
对于抗菌性试验,也获得了根据日本工业标准化法(JIS法)的试验业务单位登录制度JNLA的试验所认定。

当然,巴慕达的过滤装置也可以清洗。使用一段时间后,加湿器会自动弹出清洗滤网的提醒。
清洗后,过滤装置的效果不受影响。使用一年后,才需要更换过滤装置。


巴慕达负责蒸发水汽的涡轮风扇,不仅让加湿更有效率,也能调节冬季室内燥热。

干燥环境 还可降温
在实测中,巴慕达可以给15平米的卧室从22%加湿到31%,室温从21.8℃降温到16.9℃。

向上出风,舒适体验
同时由于不同的出风方向,巴慕达向上吹风加湿,体验上更胜一筹。即柔又绵,不比它的当家“果岭风”风扇差。

▽直吹式,吹久,呵呵...▽

▽巴慕达加湿同时,不影响工作休息▽

超低功耗,12小时只要1分钱
而且,别担心会费电(虽然用的人并不在乎)。巴慕达1档至5档的功率数,标称2W-23W,但在使用中,1档其实只有1.2瓦。

以2档功率运行34分钟,使用电量才变成了0.001。
极果君在使用时做了一个记录,前天深夜23:40以2档功率运行,次日中午12:09查看。12个小时只走了0.03度,只花了1分钱(约5毛/度)。

除菌加湿,清洗空气,巴慕达-Rain·加湿器5年前的设计,5年后依旧是行业先锋。
大容量,长续航
巴慕达标称 4.1L-6L,大水箱自然带来长续航。
实测上午10:40加满水箱,以1档运行,到晚上18:55时,巴慕达只下了一格水量(共5格)。

上加水,更便利
巴慕达特有的屏上加水,使用极为方便。充满科技感的屏上加水,是至今所有加湿器无法逾越的鸿沟。

科技大屏,操作炒鸡简单
除了屏上加水,巴慕达的操作逻辑也极其清晰。大屏显示,操控环负责上下,正前方一个按压式的确认键。

点按确认键,进入功能菜单,自动、手动、设定、24小时计时器,清洗滤网提醒。

机身上两个按键,一个为开关机键,一个为定时 。
连接电源后,也可以选择操作环上的确认键开关机,短按为开机,长按为关机。

手动模式 随心所欲 夜晚超静音
手动模式下,可以选择调节1—5档的风力,风力越强加湿效果越强,同样噪音也越大。但夜晚选择3档以下,不会影响睡眠。

1档—5档的运行声音为6db—42db。20分贝约等于人体血液流动的声音,40分贝约等于冰箱的嗡嗡声,而6分贝几乎等同针掉在地上。
个人体验,1、2档完全静音,丝毫听不到电机工作的声音,甚至因为无雾、无声,你都会怀疑它到底有没有在加湿。

太过干燥会激发病毒活性,湿度过高霉菌易于繁殖。而采用气化式加湿方式的Rain则能够营造出舒适的50%湿润度。

在我的使用过程中,醒来后再也没有任何嗓子干燥的不适感,像回到了夏天,就连钢琴都很少跑律。

童锁设计 再不怕宝宝乱动
童锁设计,长按开/关机键,就能锁定操作环。

家里的熊孩子乱动也不怕。

倾倒/震动,自动断电
加湿器里安装了灵敏的水平感应装置,只要机器有倾斜或者震动就会自动断电,更能保障安全。

就算再皮的毛孩子,也不用担心。

看看插头,可转,够人性化
还有一个极其人性化的可转化方向插头。

插不进去?换个方向就好了。


巴慕达,还没有人知道吗?2003年成立于东京,一个综合的高性能家电品牌,旨在改善用户的居家软环境。
它注重体验多过产品,尤其看重用户在拿到产品时使用的惊艳感。

Rain·加湿器外形也拿到过许多奖项。外观,历经无数次的推倒重来,设计灵感来自于东方传统加湿的器具——水罐(当然,也挺像坛子)。

尤其是Good Design Award优良设计奖(日本),被业内称为东方设计奥斯卡,是亚洲颇具权威性的设计大奖。凡是获得「G」 (Good Design)标志的产品,即代表设计和质量的双重保证。
实际体验来看,机器本身的日式质感极其到位,没有杂质、偏色,就像名窑里烧出来的陶瓷一样润眼。

《亲爱的客栈3》、《新生日记》、《爸爸回来了》、《我家那闺女》等综艺节目中,各路大牌明星都在用巴慕达。

与GOOGLE、APPLE MUSIC、AIRBNB、MR PORTER都曾登上过韩国《B》杂志。
每年固定出版十期,是世界上众多创意和设计人的常读刊物。

如果你是一个追求生活品质的人,从设计感到实用性,它都能满足你对一台加湿器的所有期望,甚至做的更好。
尤其是家里有老人小孩孕妇的,巴慕达就是保障健康的不二之选,毕竟孩子的肺不容忽视。
还在等什么,快点进来看看吧↓↓↓
【荣获各国设计大奖】日本巴慕达BALMUDA加湿器
¥3999
购买